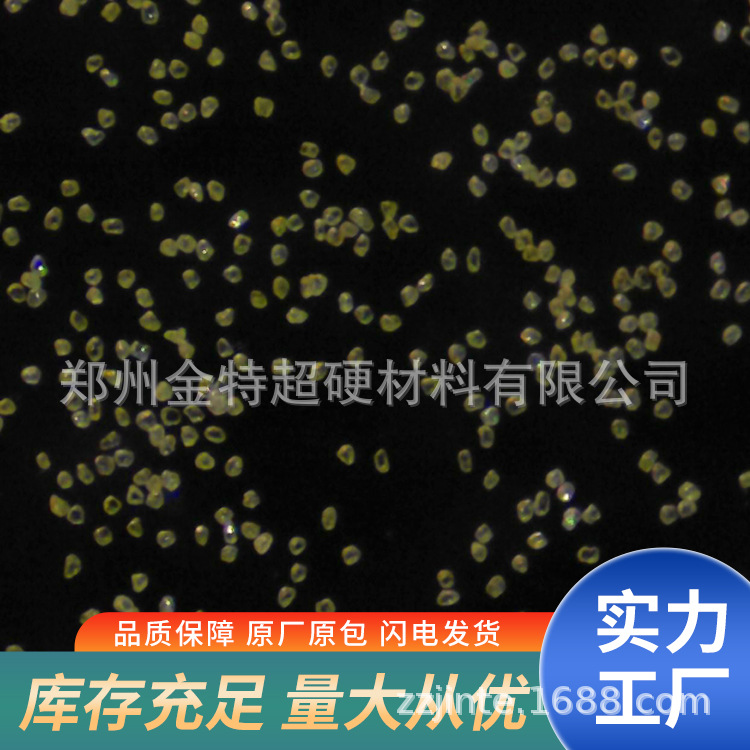
Скидка на оптовую покупку, W0.25 чистый микропорошок алмаза Zhongnan

Сверхтвердый материал из Китая: выкуп, проверка поставщика, доставка
Зарегистрируйтесь для полного функционала
Зарегистрируйтесь чтобы использовать онлайн-поиск с фильтрами по актуальной базе товаров
Товары (32)
Сортировка:

Элемент искусственный алмазный порошок 400 меш алмазный порошок высокой прочности стабильное качество алмаза второй желтый материал износостойкость
0.12 CNY / ≈ 2 ₽
Мин. заказ: 2500 шт
Рейтинг: 0.0
Продавец: 元素(柘城县)材料科技有限公司

Циркониевая керамическая кольцевая втулка, керамическая втулка, циркониевая внутренняя втулка
26 CNY / ≈ 336 ₽
Мин. заказ: 500 шт
Рейтинг: 0.0
Продавец: 苏州永佳超硬耐磨材料有限公司

3-5мкм шестиугольный борный нитрид BN порошок супер твердый 10043-11-5 борный нитрид
350 CNY / ≈ 4 517 ₽
Мин. заказ: 1 шт
Рейтинг: 0.0
Продавец: 洛阳彤润信息科技有限公司

Керамический резьбовой стержень из оксида алюминия резьбовой вал
12 CNY / ≈ 155 ₽
Мин. заказ: 1000 шт
Рейтинг: 0.0
Продавец: 苏州永佳超硬耐磨材料有限公司

500нм шестиугольный борный нитрид BN порошок супер твердый 10043-11-5 борный нитрид
600 CNY / ≈ 7 744 ₽
Мин. заказ: 1 шт
Рейтинг: 0.0
Продавец: 洛阳彤润信息科技有限公司

Порошок поликристаллического алмаза с стабильным качеством синтетический алмазный абразивный порошок поликристаллический заводская поставка
2.4 CNY / ≈ 31 ₽
Мин. заказ: 1000 шт
Рейтинг: 0.0
Продавец: 元素(柘城县)材料科技有限公司

Керамический термопроводный и высокотемпературный смазочный борный нитрид микрон содержание борного нитрида 99% борный нитрид оптовая продажа
35 CNY / ≈ 452 ₽
Мин. заказ: 1 шт
Рейтинг: 0.0
Продавец: 郑州鼎凯化工产品有限公司

Анализ алмазного материала, обнаружение компонентов, снижение формулы, анализ полупроводникового материала, диагностика процессов компонентов и неисправностей
23 CNY / ≈ 297 ₽
Мин. заказ: 1 шт
Рейтинг: 0.0
Продавец: 上海新泊地化工技术服务有限公司银川分公司

Ляонин Борода производит борный нитрид низкотемпературный шестиугольный борный нитрид 97% капсулы 1-40UM прямые продажи завода
200 CNY / ≈ 2 581 ₽
Мин. заказ: 1 шт
Рейтинг: 0.0
Продавец: 辽宁硼达科技有限公司

Полупроводниковый тонкий шлифовальный алмазный порошок зеркальная полировка карбидной формы керамическая полировка W2
0.3 CNY / ≈ 4 ₽
Мин. заказ: 5000 шт
Рейтинг: 0.0
Продавец: 东莞市福昌表面处理材料有限公司

Научный класс высокопурый алюминиевый нитрид порошок AlN термопроводная изоляция коррозионностойкая керамика высокопурый нано алюминиевый нитрид порошок
30 CNY / ≈ 387 ₽
Мин. заказ: 1 шт
Рейтинг: 5.0
Продавец: 苏州友研新材料实业有限公司

Порошок алюминиевого нитрида термопроводный изоляционный порошок порошковая металлургия смола краска промышленность доступные производители алюминиевого нитрида в наличии
68.4 CNY / ≈ 883 ₽
Мин. заказ: 1 шт
Рейтинг: 4.9
Продавец: 郑州科奇化工产品有限公司

Ляонин Бонда производит борный нитрид высокотемпературный, высокочистый шестиугольный борный нитрид с содержанием 99% и размером частиц 1-40Um
175 CNY / ≈ 2 259 ₽
Мин. заказ: 1 шт
Рейтинг: 5.0
Продавец: 辽宁硼达科技有限公司

Научные исследования высокопурый борный нитрид BN смазка шестиугольный термопроводный борный нитрид порошок высокопурый ультратонкий нано борный нитрид порошок
30 CNY / ≈ 387 ₽
Мин. заказ: 1 шт
Рейтинг: 5.0
Продавец: 苏州友研新材料实业有限公司

99.5% борный нитрид ZHPU BN-05 хорошее покрытие и скользящий эффект для косметики сильная скрывающая способность
380 CNY / ≈ 4 905 ₽
Мин. заказ: 1 шт
Рейтинг: 5.0
Продавец: 广州正朴化工有限公司

Специальные формы из борного карбида керамические изделия из борного карбида обрабатываемые изделия из борного карбида износостойкие изделия из борного карбида изогнутые изделия из борного карбида
80 CNY / ≈ 1 033 ₽
Мин. заказ: 10 шт
Рейтинг: 0.0
Продавец: 武汉持盈新材料科技有限公司

Поставка порошка борного нитрида шестиугольного борного нитрида нано борного нитрида смазка освобождения стабилизатор
35 CNY / ≈ 452 ₽
Мин. заказ: 1 шт
Рейтинг: 0.0
Продавец: 郑州瑞化源生物科技有限公司

Борный карбид керамический диск, диск для нейтронного поглощения, диск, высокоизносостойкая плита, керамическая плита из борного карбида
400 CNY / ≈ 5 163 ₽
Мин. заказ: 5 шт
Рейтинг: 0.0
Продавец: 武汉持盈新材料科技有限公司

Химическая стойкость стабильная износостойкость подходит для высокоточной обработки керамического сопла из борного нитрида
203 CNY / ≈ 2 620 ₽
Мин. заказ: 1 шт
Рейтинг: 0.0
Продавец: 江西国瓷环保科技有限公司

Поставка борного нитрида супер твердого материала керамического термопроводного высокотемпературного смазочного промышленного смазочного крупного оптового скидка
35 CNY / ≈ 452 ₽
Мин. заказ: 1 шт
Рейтинг: 0.0
Продавец: 河南千特路化工产品有限公司

Магнитный износостойкий керамический лист, антивыпадная накладка для вентилятора, высокоплотная высокотемпературная устойчивая облицовочная плита, оптовая продажа
3.5 CNY / ≈ 45 ₽
Мин. заказ: 1 шт
Рейтинг: 0.0
Продавец: 河南鼎新防腐耐磨材料有限公司

Заводской шестиугольный борный нитрид порошок микрон кубический борный нитрид порошок высокой чистоты нано борный нитрид порошок высокой теплопроводности
17 CNY / ≈ 219 ₽
Мин. заказ: 1 шт
Рейтинг: 5.0
Продавец: 河北佰科金属材料有限公司

Новая разработка Pcd Pcbn высокопроизводительных композитных вставок от Чжэнчжоу Лидинг с диаметром до 71-74 мм
1000 CNY / ≈ 12 907 ₽
Мин. заказ: 1 шт
Рейтинг: 0.0
Продавец: 郑州立钻超硬材料制品有限公司

Горячепрессованный борный карбид шестиугольный керамический лист комбинированного типа бронебойной керамической брони
80 CNY / ≈ 1 033 ₽
Мин. заказ: 1 шт
Рейтинг: 0.0
Продавец: 武汉持盈新材料科技有限公司

Алмазный дробящий материал, желтый материал, искусственный алмазный порошок 80-500 меш, Чжечэн Юшифа
0.2 CNY / ≈ 3 ₽
Мин. заказ: 200 шт
Рейтинг: 0.0
Продавец: 武汉酰多玛生物技术有限公司

Желтая река 2-алмазный дробящий материал алмазный микропорошок обработка и продажа ультратонкий
18 CNY / ≈ 232 ₽
Мин. заказ: 1 шт
Рейтинг: 4.7
Продавец: 商丘利仁超硬材料制品有限公司

Нано супер-твердый смазочный борный нитрид керамический термопроводный шестиугольный борный нитрид борный нитрид (BN) крупный оптовый скидка
36 CNY / ≈ 465 ₽
Мин. заказ: 1 шт
Рейтинг: 5.0
Продавец: 郑州琼岳化工产品有限公司

Нано-борный нитрид, шестиугольный борный нитрид, борный нитрид, косметика для смазки и освобождения, борный нитрид, отличное предложение
40 CNY / ≈ 516 ₽
Мин. заказ: 1 шт
Рейтинг: 5.0
Продавец: 河南优创化工产品有限公司

Кубический борный нитрид шестиугольный борный нитрид 10043-11-5 99% 1кг 25кг микрон
385 CNY / ≈ 4 969 ₽
Мин. заказ: 1 шт
Рейтинг: 5.0
Продавец: 武汉华翔科洁生物技术有限公司

Шестиугольный борный нитрид супер твердый материал керамический термопроводный и высокотемпературный смазочный промышленный смазочный оптовый высокопурый борный нитрид
32 CNY / ≈ 413 ₽
Мин. заказ: 1 шт
Рейтинг: 5.0
Продавец: 郑州美维化工科技有限公司

Прямые продажи завода нано-борного нитрида шестиугольного борного нитрида ультра-твердого материала высокотемпературного керамического термолубриканта
32 CNY / ≈ 413 ₽
Мин. заказ: 1 шт
Рейтинг: 4.5
Продавец: 河南耀兴化工产品有限公司
Скидка на оптовую покупку, W0.25 чистый микропорошок алмаза Zhongnan
0.1 CNY / ≈ 1 ₽
Мин. заказ: 1000 шт
Рейтинг: 0.0
Продавец: 郑州金特超硬材料有限公司
Кэш: 15920 категорий |
Обновлено: 14.11.2025, 02:20:45
